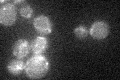
YDR194C
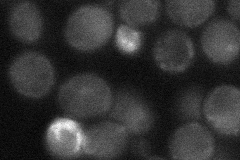
YDR194C
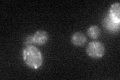
YDR194C

View description
DEAD-box protein required for efficient splicing of mitochondrial Group I and II introns; non-polar RNA helicase that also facilities strand annealing
Localization:
Intensity:
Fold change:
Significance:
-
C’ GFP library in SD
mitochondria22.67 -
N' NOP1pr-GFP in SD

mitochondria75.9032 -
N' TEF2pr-mCherry in SD

mitochondria97.3581 -
N' NATIVEpr-GFP in SD
cytosol,mitochondria22.2339 -
N' TEF2pr-VC and Cyto-VN in SD

#N/A0 -
C’ GFP library in SD+DTT
mitochondria19.690.86No -
C’ GFP library in SD+H2O2

mitochondria21.720.95No -
C’ GFP library in Starvation Media

mitochondria19.390.85No -
C’ GFP library on the background of Pup2-DaMP

mitochondria -
C’ GFP library on the background of CCT mutant

mitochondriaN/AN/ANo
